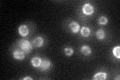
YOR098C
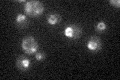
YOR098C

View description
Nuclear pore complex (NPC) subunit, involved in protein import/export and in export of RNAs, possible karyopherin release factor that accelerates release of karyopherin-cargo complexes after transport across NPC; potential Cdc28p substrate
Localization:
Intensity:
Fold change:
Significance:
-
C’ GFP library in SD
nuclear periphery38.01 -
N' NOP1pr-GFP in SD

punctate,nucleus81.1958 -
N' TEF2pr-mCherry in SD

vacuole51.8782 -
N' NATIVEpr-GFP in SD

punctate,nuclear periphery35.6381 -
N' TEF2pr-VC and Cyto-VN in SD

#N/A0 -
C’ GFP library in SD+DTT

nuclear periphery38.991.02No -
C’ GFP library in SD+H2O2

nuclear periphery38.551.01No -
C’ GFP library in Starvation Media
nuclear periphery27.690.72No -
C’ GFP library on the background of Pup2-DaMP

N/A -
C’ GFP library on the background of CCT mutant

N/A0N/AYes
